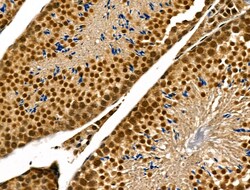
Invitrogen Phospho-p300 (Ser1834) Polyclonal Antibody 100 &mu;L | Buy Online | Invitrogen&trade; | Fisher Scientific
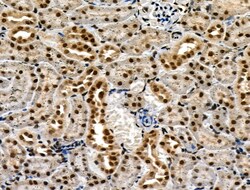
Invitrogen Phospho-p300 (Ser1834) Polyclonal Antibody 100 &mu;L | Buy Online | Invitrogen&trade; | Fisher Scientific

missing translation for 'onlineSavingsMsg'
Learn More
Learn More
Invitrogen™ Phospho-p300 (Ser1834) Polyclonal Antibody


Descripción
Antibody detects endogenous levels of KAT3B / p300 only when phosphorylated at Ser1834.
EP300 encodes the adenovirus E1A-associated cellular p300 transcriptional co-activator protein. p300 is related by sequence to CPB (CREB-binding protein [CREB: cyclic-AMP responsive element binding protein]), and like CPB can stimulate transcription through activation of CREB. This EP300 activity is specifically inhibited by the adenovirus oncoprotein E1A. EP300 has also been identified as a co-activator of HIF1A (hypoxia-inducible factor 1 alpha), and thus plays a role in the stimulation of hypoxia-induced genes such as VEGF.

Especificaciones
Especificaciones
| Antígeno | Phospho-p300 (Ser1834) |
| Aplicaciones | Immunohistochemistry (Paraffin), Western Blot |
| Clasificación | Polyclonal |
| Concentración | 1 mg/mL |
| Conjugado | Unconjugated |
| Formulación | PBS with 50% glycerol and 0.02% sodium azide; pH 7.4 |
| génica | EP300 |
| N.º de referencia del gen | B2RWS6, Q09472 |
| Alias de gen | A430090G16; A730011L11; E1A binding protein p300; E1A-associated protein p300; E1A-binding protein, 300kD; Ep300; Histone acetyltransferase p300; Histone butyryltransferase p300; Histone crotonyltransferase p300; KAT3B; P300; p300 HAT; Protein propionyltransferase p300; RSTS2 |
| Símbolos de los genes | EP300 |
| Mostrar más |
Título del producto
Al hacer clic en Enviar, acepta que Fisher Scientific se ponga en contacto con usted en relación con los comentarios que ha proporcionado en este formulario. No compartiremos su información para ningún otro fin. Toda la información de contacto proporcionada se mantendrá de acuerdo con nuestra Política de Privacidad. Política de privacidad.
¿Detecta una oportunidad de mejora?